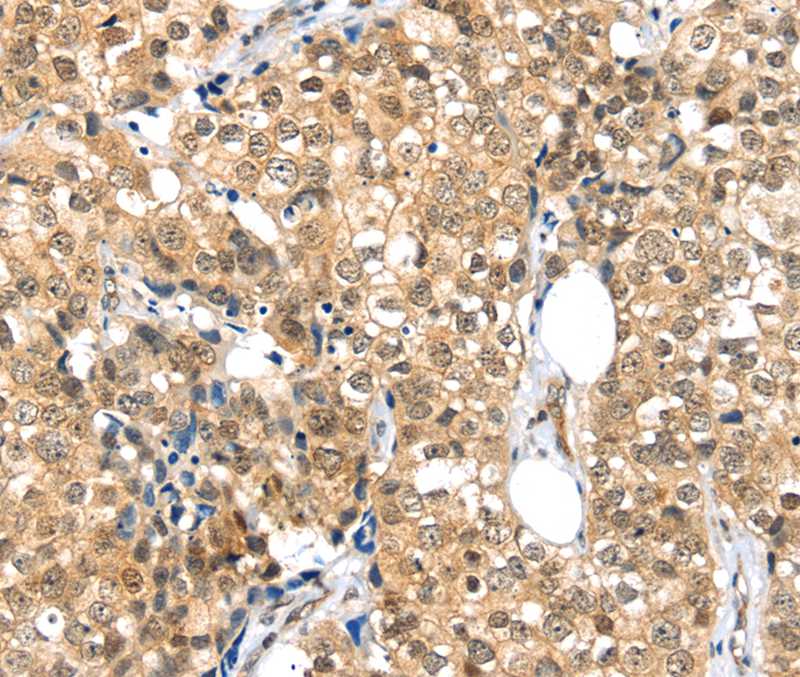

Immunohistochemical staining of human cerebellum, kidney, prostate and testis using Anti-TPR antibody HPA019663 (A) shows similar protein distribution across tissues to independent antibody HPA019661 (B).
Anti-TPR-25ul
HPA019663
ApplicationsWestern Blot, ImmunoCytoChemistry, ImmunoHistoChemistry
Product group Antibodies
ReactivityHuman
Overview
- SupplierAtlas Antibodies
- Product NameAnti-TPR-25ul
- Delivery Days Customer6
- ApplicationsWestern Blot, ImmunoCytoChemistry, ImmunoHistoChemistry
- Applications SupplierWB, ICC, IHC
- CertificationResearch Use Only
- ClonalityPolyclonal
- Concentration0.1
- ConjugateUnconjugated
- HostRabbit
- IsotypeIgG
- Protein IDP12270
- Protein NameNucleoprotein TPR
- Scientific DescriptionRabbit Polyclonal Anti-TPR Antibody against Human translocated promoter region, nuclear basket protein. Validated for Immunofluorescence, Immunohistochemistry and Western Blot
- ReactivityHuman
- Storage InstructionStore at +4°C for short term storage. Long time storage is recommended at -20°C.
- UNSPSC12352203